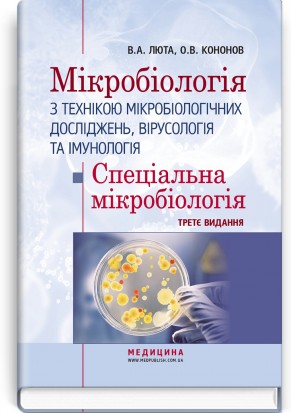

Содержание книги Мікробіологія з технікою мікробіологічних досліджень, вірусологія та імунологія. Спеціальна мікробіологія / В.А. Люта, О.В. Кононов. — 3-є видання
ВІД АВТОРІВ
ДОПУЩЕНІ СКОРОЧЕННЯ
ЧАСТИНА I. СПЕЦІАЛЬНА МІКРОБІОЛОГІЯ
Патогенні коки
Грампозитивні коки
Стафілококи
Стрептококи
Пневмококи
Ентерококи
Грамнегативні коки
Менінгококи
Гонококи
Короткі відомості про мораксели, ацинетобактер, кінгели, олігели
Збудники кишкових інфекцій. Умовнопатогенні бактерії
Ешерихії
Сальмонели
Черевний тиф і паратифи А і В
Збудники харчових токсикоінфекцій
Шигели
Умовнопатогенні бактерії. Методи діагностики дисбактеріозу
Клебсієли
Протей
Ієрсинії
Синьогнійна паличка
Короткі відомості про кампілобактерії, гелікобактер, ентеробактер, цитробактер, серацію
Кампілобактерії. Гелікобактер
Ентеробактер. Цитробактер. Серація
Збудники особливо небезпечних інфекцій
Холерні вібріони
Збудник чуми
Збудник туляремії
Збудники бруцельозу
Збудник сибірки
Збудники бактерійних повітрянокраплинних інфекцій
Бордетели
Коринебактерії дифтерії
Лістерії
Мікобактерії туберкульозу
Мікобактерії лепри
Легіонели
Патогенні анаероби
Клостридії
Збудник правця
Збудник ботулізму
Збудники газової гангрени
Патогенні бактероїди
Патогенні спірохети
Трепонеми
Борелії
Збудники поворотного тифу
Збудник системного кліщового бореліозу (хвороба Лайма)
Лептоспіри
Рикетсії
Збудник епідемічного висипного тифу
Збудник ендемічного висипного тифу
Збудник гарячки Ку
Хламідії
Мікоплазми
Актиноміцети
Патогенні гриби
Збудники поверхневих мікозів
Збудники кандидозів
Віруси
Віруси — збудники гострих респіраторних вірусних інфекцій
Ортоміксовіруси
Параміксовіруси
Віруси парагрипу
Вірус епідемічного паротиту
Вірус кору
Респіраторносинцитіальний вірус
Аденовіруси
Вірус краснухи
Коронавіруси
SARSCoV2 – збудник гострого респіраторного дистрессиндрому
Віруси — збудники гострих кишкових інфекцій
Вірус поліомієліту
Віруси Коксакі
Віруси ECHO
Ротавіруси
Вірус норфолк
Віруси гепатитів
Вірус гепатиту А
Вірус гепатиту В
Вірус гепатиту С
Вірус гепатиту Е
Вірус гепатиту D
Герпесвіруси
Віруси простого герпесу
Вірус вітряної віспи
Цитомегаловірус
Вірус Епштейна—Барр
Поксвіруси. Вірус натуральної віспи
Вірус кліщового енцефаліту
Вірус сказу
Ретровіруси
Вірус імунодефіциту людини
КЛІНІЧНА МІКРОБІОЛОГІЯ
САНІТАРНА МІКРОБІОЛОГІЯ
ЧАСТИНА ІІ. ПРАКТИЧНІ ЗАНЯТТЯ
Практичне заняття № 25. Стафілококи. Стрептококи. Виготовлення поживних середовищ, відбір патологічного матеріалу, проведення первинного посіву
І. Виготовлення поживних середовищ — ЖСА і КА
ІІ. Відбір патологічного матеріалу для дослідження, заповнення направлення, підготовка матеріалу до транспортування та дослідження
ІІІ. Проведення первинного посіву патологічного матеріалу на поживні середовища
ІV. Вивчення схеми лабораторного дослідження з метою виявлення та ідентифікації стафілококів .
Практичне заняття № 26. Стафілококи. Стрептококи. Виділення чистої культури стафілококів. Вивчення етапів ідентифікації стрептококів
І. Визначення колоній стафілококів і стрептококів за їх культуральними ознаками; вивчення культуральних властивостей мікроорганізмів на цукровому бульйоні
ІІ. Визначення морфології та тинкторіальних властивостей стафілококів і стрептококів
ІІІ. Виділення чистої культури стафілококів
ІV. Вивчення схеми лабораторного дослідження з метою виявлення та ідентифікації S.pyogenes
Практичне заняття № 27. Стафілококи. Стрептококи. Ідентифікація культури стафілококів
І. Вивчення культуральних властивостей стафілокока на скошеному МПА, перевірка чистоти культури .
ІІ. Визначення ферментативних властивостей стафілококів .
ІІІ. Посів культури стафілокока з метою визначення його фаговаріанту
ІV. Посів культури стафілокока з метою визначення чутливості до антибіотиків .
V. Ознайомлення зі схемою лабораторного дослідження з метою виявлення та ідентифікації S. pneumonіae
Практичне заняття № 28. Менінгококи. Гонококи
І. Проведення обліку та оформлення результатів ідентифікації стафілококів
ІІ. Виготовлення поживних середовищ для культивування менінгококів .
ІІІ. Відбір патологічного матеріалу з носоглотки у разі підозри на менінгококову інфекцію, ознайомлення з методикою взяття спинномозкової рідини
ІV. Проведення первинного посіву матеріалу, створення умов для культивування менінгокока
V. Виявлення менінгококів у препаратах за їх морфологічними та тинкторіальними властивостями
VІ. Ознайомлення зі схемою лабораторної діагностики менінгококової інфекції
VІІ. Виявлення гонококів у препаратах за їх морфологічними та тинкторіальними властивостями
VІІІ. Ознайомлення зі схемою лабораторної діагностики гонореї
Практичне заняття № 29. Модульний контроль з тем «Загальна мікробіологія» та «Патогенні коки» (орієнтовна методика проведення підсумкового заняття)
І. Проведення тестового контролю
ІІ. Проведення контролю практичних навичок, розв’язування ситуаційних задач
Практичне заняття № 30. Ешерихії. Відбір патологічного матеріалу, посів, первинна ідентифікація ешерихій
І. Виготовлення поживних середовищ для культивування ешерихій .
ІІ. Відбір фекалій для дослідження, їх посів на диференціальнодіагностичні середовища .
ІІІ. Проведення первинної ідентифікації ешерихій, виділення чистої культури діареєгенних E. colі
ІV. Вивчення схеми виділення та ідентифікації діареєгенних E. colі
Практичне заняття № 31. Ешерихії. Визначення роду, виду, сероваріанту ешерихій
І. Проведення обліку росту культури на середовищі первинної ідентифікації
ІІ. Пересівання культури з середовища первинної ідентифікації на середовища мінімального диференціюючого ряду .
ІІІ. Проведення серологічної ідентифікації культури
Практичне заняття № 32. Сальмонели. Проведення бактеріологічного дослідження
І. Облік результатів посіву ешерихій на середовищах короткого диференціюючого ряду і результатів РА
ІІ. Ознайомлення з правилами відбору патологічного матеріалу для бактеріологічного дослідження на різних стадіях хвороби сальмонельозної етіології
ІІІ. Посів патологічного матеріалу на середовища первинного посіву
ІV. Відбір підозрілих колоній, їх пересівання на комбіноване середовище первинної ідентифікації
V. Вивчення біохімічних властивостей сальмонел
VІ. Визначення антигенної структури сальмонел
VІІ. Вивчення схеми виділення та ідентифікації сальмонел
Практичне заняття № 33. Сальмонели. Фаготипування сальмонел черевного тифу
І. Визначення культуральних і ферментативних властивостей сальмонел на середовищах (облік результатів попередніх посівів)
ІІ. Ознайомлення з принципом фаготипування S. typhі
ІІІ. Підготовка культури S. typhі і чашок Петрі з МПА до фаготипування
IV. Проведення посіву культури, нанесення фагів
V. Ознайомлення з методикою оцінювання результатів фаготипування
Практичне заняття № 34. Сальмонели. Серологічна діагностика черевного тифу, паратифів А і В та бактеріоносійства
І. Облік результатів фаготипування культури S. typhі
ІІ. Ознайомлення з особливостями серологічного методу діагностики захворювань сальмонельозної етіології
ІІІ. Ознайомлення з видами та формою випуску діагностикумів
ІV. Постановка реакції аглютинації Відаля
V. Постановка реакції Vігемаглютинації
Практичне заняття № 35. Шигели. Виділення та ідентифікація культури
І. Виготовлення диференціальнодіагностичних середовищ з антибіотиком і без нього
ІІ. Посів фекалій на виготовлені поживні середовища
ІІІ. Вивчення культуральних, морфологічних і тинкторіальних властивостей шигел
ІV. Визначення ферментативних властивостей шигел на середовищі первинної ідентифікації (Ресселя або Олькеницького)
V. Визначення належності культури до роду Shіgella
VІ. Визначення чутливості виділеної культури до антибіотиків
Практичне заняття № 36. Шигели. Визначення виду шигел. Серологічна діагностика шигельозу
І. Визначення ферментативних властивостей шигел на середовищах мінімального диференціюючого ряду
ІІ. Проведення серологічної ідентифікації шигел
ІІІ. Визначення чутливості виділеної культури до антибіотиків, формулювання відповіді
ІV. Ознайомлення зі схемою виділення та ідентифікаціїї шигел
V. Ознайомлення з принципами проведення серологічної діагностики шигельозу та бактеріоносійства
Практичне заняття № 37. Умовнопатогенні бактерії. Виявлення дисбактеріозу кишечнику
І. Підготовка фекалій до дослідження
ІІ. Проведення посіву фекалій методом розведення
ІІІ. Посів фекалій спрощеним методом Гоулда
ІV. Оцінювання результатів дослідження
Практичне заняття № 38. Модульний контроль з тем: «Ентеробактерії. Умовнопатогенні бактерії. Дисбактеріоз»
І. Перевірка теоретичних знань
ІІ. Проведення контролю практичних навичок, розв’язування ситуаційних задач
Практичне заняття № 39. Холерні вібріони
І. Виготовлення 1% пептонної води та агару лужного
ІІ. Ознайомлення з правилами відбору патологічного матеріалу у хворого або особи, підозрілої щодо захворювання на холеру, для бактеріологічного дослідження. Посів фекалій на виготовлені поживні середовища
ІІІ. Вивчення культуральних, морфологічних і тинкторіальних властивостей культури холерних вібріонів
ІV. Проведення орієнтовної РА з імунними протихолерними аглютинуючими діагностичними сироватками («О», «RO» та О139), оформлення результатів
V. Ознайомлення з методикою використання систем індикаторних паперових (СІП) для ідентифікації вібріонів
VI. Ознайомлення зі схемою виділення та ідентифікації холерних вібріонів
VII. Ознайомлення з прискореними методами діагностики холери
Практичне заняття № 40. Збудники чуми та туляремії
І. Ознайомлення з режимом роботи лабораторії ОНІ
ІІ. Ознайомлення з типами протичумних костюмів і правилами їх використання
ІІІ. Визначення морфології та тинкторіальних властивостей збудників чуми і туляремії у мікропрепаратах
ІV. Проведення розгорнутої РА для серологічної діагностики туляремії
V. Складання схеми виділення та ідентифікації збудників чуми і туляремії
Практичне заняття № 41. Збудники бруцельозу, сибірки
І. Визначення морфології та тинкторіальних властивостей збудників бруцельозу і сибірки у мікропрепаратах
ІІ. Проведення орієнтовної РА Хеддльсона для діагностики бруцельозу
ІІІ. Проведення розгорнутої РА Райта для серологічної діагностики бруцельозу
ІV. Складання графічної схеми виділення та ідентифікації збудників бруцельозу
V. Проведення РП за Асколі з метою виявлення антигену збудника сибірки
VІ. Складання графічної схеми виділення та ідентифікації збудника сибірки
Практичне заняття № 42. Бордетели
І. Відбір патологічного матеріалу для дослідження у разі підозри на коклюш
ІІ. Проведення первинного посіву на середовища КВА та Борде—Жангу
ІІІ. Вивчення культуральних властивостей бордетел
IV. Визначення морфології та тинкторіальних властивостей бордетел у мікропрепаратах, виділення їх чистої культури
V. Проведення посіву з метою визначення біохімічних властивостей бордетел
VІ. Визначення антигенної структури бордетел
VІІ. Складання графічної схеми виділення та ідентифікації культури бордетел
VІІІ. Ознайомлення з препаратами вакцин АКДП і АаКДП
Практичне заняття № 43. Коринебактерії дифтерії. Виготовлення поживних середовищ, відбір та первинний посів патологічного матеріалу. Проведення первинної ідентифікації культури
І. Виготовлення поживних середовищ — КА, КТА та сироваткового агару
ІІ. Відбір патологічного матеріалу, заповнення направлення, підготовка матеріалу до транспортування
ІІІ. Проведення первинного посіву патологічного матеріалу
IV. Вивчення культуральних властивостей коринебактерій, визначення морфології та тинкторіальних властивостей коринебактерій у мікропрепаратах
V. Проведення посіву матеріалу з метою виділення чистої культури коринебактерій, виявлення їх токсигенності і цистинази
VІ. Вивчення схеми виділення та ідентифікації культури коринебактерій
Практичне заняття № 44. Коринебактерії дифтерії. Вивчення ферментативної активності коринебактерій. Оцінка результатів дослідження
І. Облік результатів попередніх посівів (визначення токсигенності коринебактерій і цистинази)
ІІ. Перевірка чистоти культури коринебактерій
ІІІ. Пересів культури коринебактерій з метою вивчення біохімічних властивостей
ІV. Ознайомлення з правилами використання СІП
V. Ознайомлення з імунопрепаратами для профілактики та лікування дифтерії
Практичне заняття № 45. Мікобактерії туберкульозу
І. Облік результатів попередніх посівів
ІІ. Ознайомлення зі способами відбору патологічного матеріалу для мікробіологічного дослідження та умовами його транспортування
ІІІ. Ознайомлення з методами виявлення мікобактерій туберкульозу та із поживними середовищами для культивування мікобактерій туберкульозу
ІV. Проведення мікроскопічного дослідження мокротиння
V. Вивчення схеми бактеріологічної діагностики туберкульозу
VІ. Ознайомлення з препаратами для профілактики та лікування туберкульозу
Практичне заняття № 46. Патогенні анаероби (клостридії, бактероїди)
І. Виготовлення поживних середовищ Вільсона—Блера та КА
ІІ. Ознайомлення з правилами відбору матеріалу для дослідження з метою виявлення анаеробів. Виготовлення суспензії ґрунту для дослідження
ІІІ. Посів суспензії ґрунту на поживні середовища, створення умов для культивування анаеробів
ІV. Виявлення клостридій та бактероїдів у мікропрепаратах
V. Ознайомлення з методами виявлення токсину C.tetanі в патологічному матеріалі та бульйонній культурі
VІ. Вивчення імунологічних препаратів, які застосовують для профілактики та лікування захворювань, спричинених анаеробами
VІІ. Складання графічних схем, вивчення методів мікробіологічної діагностики захворювань, спричинених клостридіями та бактероїдами
Практичне заняття № 47. Патогенні спірохети
І. Проведення обліку результатів попередніх посівів
ІІ. Вивчення морфологічних і тинкторіальних властивостей трепонем, борелій, лептоспір
ІІІ. Вивчення методів мікробіологічної діагностики сифілісу, проведення реакції Вассерманна
ІV. Ознайомлення з методами мікробіологічної діагностики бореліозів
V. Вивчення методів мікробіологічної діагностики лептоспірозу
Практичне заняття № 48. Рикетсії. Актиноміцети. Патогенні гриби
І. Вивчення методів мікробіологічної діагностики висипного тифу
ІІ. Постановка РА для діагностики висипного тифу
ІІІ. Вивчення методів мікробіологічної діагностики гарячки Ку
IV. Ознайомлення зі способами відбору патологічного матеріалу та методами мікробіологічної діагностики захворювань, спричинених актиноміцетами, дерматоміцетами та грибами роду Candіda
V. Відбір зскрібків, виготовлення препаратів, їх мікроскопія
VI. Визначення морфологічних властивостей збудників актиномікозу, дерматомікозів і кандидозів у виготовлених препаратах
Практичне заняття № 49. Віруси
І. Ознайомлення із завданнями та особливостями режиму роботи вірусологічної лабораторії
ІІ. Ознайомлення з методами культивування вірусів, їх індикації та ідентифікації
ІІІ. Ознайомлення з методами відбору матеріалу при вірусних інфекціях, упаковкою та умовами його транспортування до лабораторії
ІV. Відбір вірусовмісного матеріалу при ГРВІ, підготовка його до транспортування
Практичне заняття № 50. Віруси
I. Вивчення властивостей вірусів, патогенезу і клінічної картини вірусних інфекцій, методів мікробіологічної діагностики хвороб, спричинених ортоміксовірусами, параміксовірусами, коронавірусами, рабдовірусами, пікорнавірусами, арбовірусами, поксвірусами, вірусами гепатитів, ВIЛ і ротавірусами
ІІ. Ознайомлення з Календарем щеплень і препаратами для активної та пасивної специфічної профілактики вірусних інфекцій
Практичне заняття № 51. Модульний контроль з тем: «ОНІ», «Бордетели», «Коринебактерії», «Мікобактерії», «Патогенні анаероби», «Спірохети», «Рикетсії», «Актиноміцети», «Патогенні гриби», «Віруси»
І. Перевірка теоретичних знань
ІІ. Контроль практичних навичок
ІІІ. Розв’язувння ситуаційних задач
Практичне заняття № 52. Санітарномікробіологічні дослідження води та напоїв
І. Ознайомлення з нормативною документацією, яка регламентує відбір, санітарномікробіологічні дослідження, а також гігієнічні вимоги щодо води
ІІ. Відбір проб питної води централізованого водопостачання, підготовка її до транспортування
ІІІ. Проведення посіву води з метою визначення БГКП (І етап дослідження)
IV. Проведення посіву води з метою визначення ЗМЧ
V. Ознайомлення з методикою визначення ентерококів
VI. Ознайомлення з методикою визначення коліфагів
VII. Ознайомлення зі схемою проведення санітарномікробіологічного дослідження питної води
VIII. Ознайомлення з методами відбору проб та проведення санітарномікробіологічного дослідження безалкогольних і слабоалкогольних напоїв
Практичне заняття № 53. Санітарномікробіологічне дослідження повітря
І. Облік результатів посіву води на середовища накопичення ГПС і МПА (продовження мікробіологічного дослідження питної води — ІІ етап дослідження)
ІІ. Ознайомлення з методами мікробіологічного дослідження повітря
ІІІ. Відбір проб повітря седиментаційним і аспіраційним методами
ІV. Ознайомлення зі схемою проведення та критеріями оцінювання санітарномікробіологічного дослідження повітря в акушерських стаціонарах
Практичне заняття № 54. Санітарномікробіологічне дослідження ґрунту
І. Продовження санітарномікробіологічного дослідження питної води (ІІІ етап дослідження)
ІІ. Облік результатів посіву повітря
ІІІ. Ознайомлення з методами санітарномікробіологічного аналізу та правилами відбору проб ґрунту для санітарномікробіологічного дослідження
IV. Підготовка проб ґрунту до санітарномікробіологічного дослідження
V. Проведення скороченого санітарномікробіологічного аналізу ґрунту
VІ. Ознайомлення зі схемою проведення та критеріями оцінювання результатів санітарномікробіологічного дослідження ґрунту
Практичне заняття № 55. Санітарномікробіологічне дослідження молока, молочних продуктів і кондитерських виробів з кремом
І. Продовження санітарномікробіологічного дослідження питної води (ІV етап дослідження). Облік результатів посіву ґрунту
II. Ознайомлення з нормативною документацією, що регламентує проведення санітарномікробіологічного контролю молока і молочнокислих продуктів, правилами відбору проб та умовами транспортування
III. Проведення санітарномікробіологічного дослідження молока з метою визначення у ньому БГКП і ЗМЧ
ІV. Визначення специфічної мікрофлори у молочнокислих продуктах
V. Ознайомлення з методикою якісного визначення антибіотиків і сульфаніламідних препаратів у молоці та інших продуктах харчування
VІ. Ознайомлення зі схемою санітарномікробіологічного дослідження молока і молочних продуктів
VІІ. Ознайомлення з особливостями проведення санітарномікробіологічного дослідження продукції дитячої молочної кухні
VIII. Ознайомлення зі схемою санітарномікробіологічного дослідження кондитерських виробів з кремом. Підготовка і проведення посіву крему з метою визначення БГКП, ЗМЧ (МАФАМ) та кількості коагулазопозитивних стафілококів
Практичне заняття № 56. Санітарномікробіологічне дослідження кулінарних і м’ясоковбасних виробів
I. Облік результатів посівів молока та вершкового крему
II. Ознайомлення із загальними вимогами до якості кулінарної продукції та з нормативною документацією, що регламентує відбір проб цієї продукції, її транспортування, зберігання, а також дослідження та оцінювання якості
ІІІ. Ознайомлення з правилами відбору проб кулінарної продукції та м’ясоковбасних виробів для санітарномікробіологічного дослідження
ІV. Ознайомлення з підготовкою проб кулінарних і м’ясних виробів до санітарномікробіологічних досліджень
V. Підготовка проб ковбаси до санітарномікробіологічного дослідження
VI. Проведення посіву проб ковбаси з метою її санітарномікробіологічного дослідження
VII. Ознайомлення з методикою визначення БГКП методом НВЧ (найбільш вірогідного числа)
VIII. Ознайомлення зі схемою проведення санітарномікробіологічного дослідження кулінарних і м’ясоковбасних виробів
Практичне заняття № 57. Санітарномікробіологічне дослідження консервів
I. Облік результатів посівів м’ясоковбасних виробів
II. Ознайомлення з визначенням і класифікацією консервів
ІІІ. Ознайомлення з НД, що регламентує відбір проб, методи дослідження та оцінювання якості банкових консервів
IV. Ознайомлення з правилами відбору проб банкових консервів для санітарномікробіологічного дослідження
V. Підготовка банкових консервів до проведення санітарномікробіологічного дослідження
VІ. Проведення санітарномікробіологічного дослідження банкових консервів на промислову стерильність
VІІ. Ознайомлення з методикою оцінювання якості банкових консервів
Практичне заняття № 58. Санітарномікробіологічне дослідження хірургічного та перев’язувального матеріалу на стерильність
І. Облік результатів посівів банкових консервів
ІІ. Ознайомлення з НД, яка регламентує санітарномікробіологічний контроль у лікувальнопрофілактичних закладах
ІІІ. Ознайомлення з правилами підготовки та відбору проб на стерильність
IV. Проведення санітарномікробіологічного дослідження хірургічного матеріалу на стерильність
V. Облік результатів дослідження, оформлення відповіді
Практичне заняття № 59. Санітарномікробіологічне дослідження змивів з рук та обладнання. Мікробіологічний контроль за якістю дезінфекції
I. Облік результатів посівів на стерильність
ІІ. Ознайомлення з НД, яка регламентує проведення санітарномікробіологічного обстеження об’єктів довкілля методом змивів і контроль якості дезінфекції
ІІІ. Ознайомлення з методами відбору змивів з різних об’єктів, правилами оформлення супровідної документації та умовами транспортування змивів до лабораторії
ІV. Ознайомлення з методами контролю якості дезінфекції
V. Відбір змивів з рук і лабораторного стола, проведення посівів з метою визначення мікробного забруднення
Практичне заняття № 60. Модульний контроль з теми: «Санітарна мікробіологія»
І. Облік результатів попереднього посіву
II. Проведення модульного контролю
КОРОТКИЙ СЛОВНИК ТЕРМІНІВ
ЛІТЕРАТУРА


 01054, г. Киев, ул.
01054, г. Киев, ул.

Архив содержит книги, которых нет в наличии, но которые в ближайшее время, возможно,
Архив содержит книги, которых нет в наличии, но которые в ближайшее время, возможно,